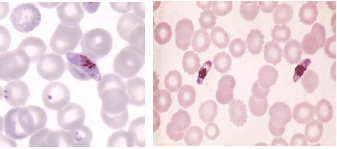
Enunciado 792665-1

Foram encontradas 1.170 questões.
Um homem de 45 anos, caminhoneiro, residente em Aparecida de Goiânia, voltou de uma viagem que fez a trabalho à região Norte do Brasil, onde permaneceu por oito dias. Ele apresentava os seguintes sintomas: quadro de mal-estar, dor de cabeça, cansaço e dor muscular, que evoluíram para episódios de febre intermitente, com periodicidade de 48 em 48 horas. Procurou uma unidade de saúde, e o médico solicitou a realização de pesquisa de parasitos em sangue periférico. As formas parasitárias encontradas foram as seguintes:
Disponível em: <http://dpd.cdc.gov/dpdx/
html; http://www.icb.usp.br/~livropar/ img/capitulo2/8.html> Acesso em 10 mar. 2012.
De acordo com as imagens, as morfologias das formas sanguíneas encontradas correspondem a gametócitos de
Provas
Questão presente nas seguintes provas
O serviço social, no Brasil foi criado pelas mãos da Igreja Católica, sob a égide do
Provas
Questão presente nas seguintes provas
No sistema operacional Microsoft Windows 7 ©, na ferramenta Windows Explorer, o usuário pode exibir ou ocultar as extensões dos arquivos contidos em um diretório, conforme mostram Figura A (com extensão) e Figura B (sem extensão).

A sequência correta de ações (passos), na ferramenta Windows Explorer, para exibir as extensões dos arquivos é:
Provas
Questão presente nas seguintes provas
De acordo com Netto (1991), o processo de reconceituação do serviço social brasileiro ocorreu por meio de diferentes perspectivas, na seguinte ordem:
Provas
Questão presente nas seguintes provas
Observe a figura a seguir.

No passo 1, um host (192.168.0.1) envia um pacote em broadcast (FF:FF:FF:FF:FF:FF), contendo o endereço IP de outro host (192.168.0.3). No passo 2, outro host envia um pacote de resposta com seu respectivo endereço Ethernet (00:C2:11:FE:8E:48) ao primeiro host. Esse mapeamento de endereços da camada de enlace para endereços da camada de rede é a função de um protocolo da camada de rede da arquitetura TCP/IP chamado:
Provas
Questão presente nas seguintes provas
Transferência é a operação que visa a separar os documentos em uso daqueles que perderam sua validade ou utilidade prática, mas não seu valor. Dessa forma, a transferência é pautada em critérios. São eles:
Provas
Questão presente nas seguintes provas
As funções da fixação de peças anatômicas são:
Provas
Questão presente nas seguintes provas
Em um experimento farmacológico, o resultado obtido apresentou distribuição normal e a droga estudada possui efeito significativo com p<0,05. Esse dado indica, na população estudada, que há probabilidade de
Provas
Questão presente nas seguintes provas
Os tipos de Arquivos correspondem à frequência de seu uso ou consulta e podem ser classificados em:
Provas
Questão presente nas seguintes provas
A nefrocalcinose em prematuros que necessitam de cuidados de terapia intensiva é de etiologia multifatorial e resultante do desbalanço entre os fatores promotores e inibidores da litogênese. A precipitação mineral mais comum é:
Provas
Questão presente nas seguintes provas
Cadernos
Caderno Container